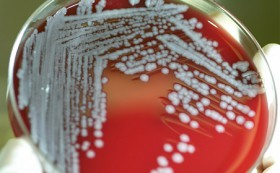

-

До чемпионата мира ровно год
Общество -

Час «икс» назначен на завтра
Общество -

Предстоит жеребьевка
Общество -

Городская набережная преображается
Общество -

Заграничный Айболит для нашего Шарика
Общество -

Ирония судьбы по-елабужски
Общество -

Учитывая «послужной список» фанатов
Общество -

Сфотографируйте республику на память
Общество -

Десять кошмаров барышни с кредиткой
Общество -
И снова сибирская язва
Общество -
8 августа 08.08.2014
История Татарстана -

Пытался незаконно ввезти огнестрельный раритет
Происшествия -

Николай ФЕДОРОВ, глава Минсельхоза, о годовом запрете на ввоз в РФ мяса, фруктов, сыров, молока из стран ЕС, США, Австралии, Канады и Норвегии
Мнение -

Как ситуация на полях?
Сельское хозяйство -

Оптимизация через «большой налоговый маневр»
Экономика